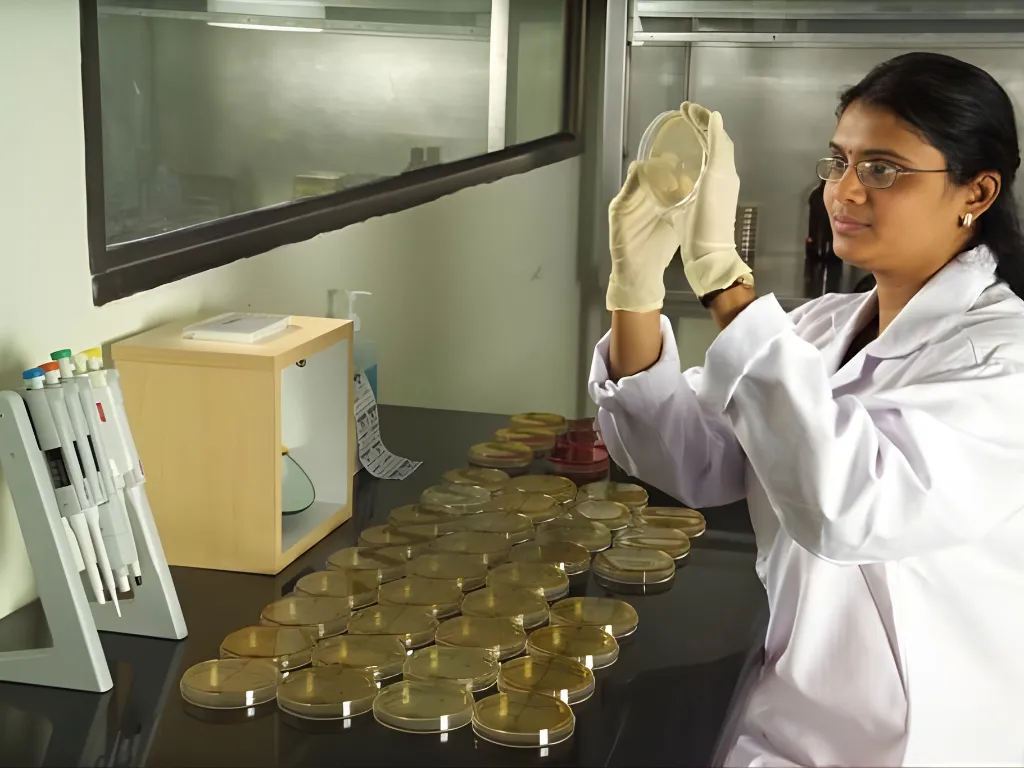

Analytical Services
- Home
- »
- Analytical Services

We deliver precise and reliable analytical services, ensuring your products meet stringent quality and compliance standards.
Comprehensive Service Offerings
Method Development and Validation
Our validations ensure methods meet sensitivity, specificity, and reliability requirements for consistent, high-quality results.
Reference Standard Qualification
Through rigorous assessments, we ensure these standards meet quality benchmarks, enabling reliable outcomes.
Isolation and Characterization of Impurities
From detection to characterization, our expertise guarantees precise impurity management.
Forced Degradation Studies
Our stress-testing protocols evaluate drug stability under extreme conditions, helping you understand degradation pathways and product resilience.
Stability Studies
Anthem’s state-of-the-art stability chambers provide reliable data for regulatory needs and storage guidelines.
Physicochemical Properties Analysis
Our analysis of solubility, pH, and other physical and chemical properties ensures product quality and formulation optimization.
Polymorphism Studies
By identifying and characterizing polymorphic forms of APIs, we help enhance drug stability, solubility, and bioavailability.
Chiral Separation
Anthem specializes in chiral separations using DAC and large-scale columns, ensuring the highest purity levels for enantiomers.
Specialized Analytical Techniques
-
NMR Spectroscopy
-
Heavy Metal Analysis
-
Residue and Impurity Testing
-
Chiral Analysis
-
Thermal Analysis (DSC/DTG)

Expertise in small molecule analytics

Commitment to quality and compliance

